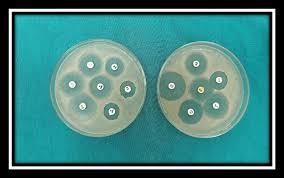

Antimicrobial Susceptibility Test Market Technological Advancements Transforming Diagnostic Laboratories Globally
Antimicrobial susceptibility test market is critical for detecting resistant pathogens, guiding targeted antibiotic therapy, and enhancing laboratory efficiency. Technological advancements are transforming diagnostic laboratories globally, enabling faster, more accurate, and scalable antimicrobial susceptibility testing. Automation, molecular diagnostics, digital integration, and artificial intelligence (AI) are enhancing clinical diagnostics, research capabilities, and laboratory workflows. Understanding these innovations helps companies and healthcare facilities optimize operations, improve patient outcomes, and strengthen global adoption. The market is witnessing sustained growth as laboratories implement advanced technologies to meet increasing demand for accurate and rapid testing.
Automation Enhancing Laboratory Efficiency
Automation is a key technological advancement shaping diagnostic laboratories. Automated platforms streamline sample preparation, inoculation, incubation, and result analysis with minimal manual intervention. This reduces human error, increases throughput, and ensures consistent, reproducible results. Integration with laboratory information management systems (LIMS) improves data handling, reporting accuracy, and regulatory compliance. Automation enables laboratories to manage higher sample volumes efficiently while maintaining quality standards. Adoption of automated solutions enhances workflow efficiency, accelerates turnaround times, and supports laboratories in delivering reliable antimicrobial susceptibility results for clinical and research applications.
Molecular Diagnostics for Rapid Detection
Molecular diagnostic technologies are revolutionizing susceptibility testing by providing rapid, precise identification of resistance genes and multidrug-resistant pathogens. Techniques such as PCR and next-generation sequencing complement traditional culture-based methods by delivering faster results. Molecular diagnostics allow laboratories to implement targeted antibiotic therapy, improving patient outcomes and reducing the spread of resistant pathogens. Integration with automated platforms enhances throughput and ensures accurate, timely results. Molecular innovations also support research efforts, enabling laboratories to study resistance mechanisms, evaluate novel therapeutics, and monitor epidemiological trends effectively.
AI and Digital Integration
Artificial intelligence (AI) and digital integration are transforming laboratory operations and data analysis. AI algorithms analyze large datasets to predict resistance patterns, optimize workflows, and enhance laboratory decision-making. Digital tools facilitate remote monitoring, automated reporting, and data sharing between clinical and research laboratories. Combined with automation and molecular diagnostics, AI improves accuracy, efficiency, and scalability in antimicrobial susceptibility testing. Adoption of AI-driven solutions enables laboratories to identify emerging threats, streamline testing processes, and implement evidence-based interventions that support clinical diagnostics and public health initiatives.
Clinical Applications
Technological advancements in susceptibility testing have significant clinical implications. Rapid and accurate testing supports targeted antibiotic therapy, reduces inappropriate antibiotic use, and enhances infection control measures. Point-of-care testing is becoming increasingly feasible, allowing immediate treatment decisions in hospitals and outpatient facilities. Integration with hospital information systems ensures seamless data management, regulatory compliance, and timely reporting. Advanced technologies allow laboratories to deliver reliable results, improve patient outcomes, and enhance operational efficiency, making them essential for modern clinical diagnostics and infection management strategies.
Research Applications
Research laboratories also benefit from technological innovations in antimicrobial susceptibility testing. Automated platforms, molecular diagnostics, and AI enable detailed analysis of microbial resistance, identification of emerging pathogens, and evaluation of new therapeutics. High-throughput testing, accurate data collection, and predictive analytics facilitate epidemiological research and support evidence-based policy decisions. Technological advancements ensure laboratories can conduct studies efficiently, monitor global resistance trends, and provide critical insights for both clinical and public health applications.
Regional Adoption Trends
North America and Europe lead in technological adoption due to advanced infrastructure, regulatory frameworks, and high awareness of antimicrobial resistance. Laboratories in these regions implement automated and molecular platforms, AI, and digital integration to optimize workflows. Asia Pacific is emerging as a growth market, driven by modernization of healthcare infrastructure, laboratory expansion, and increased demand for rapid diagnostics. Latin America, the Middle East, and Africa show gradual adoption as infrastructure and awareness improve. Understanding regional trends allows companies to tailor solutions, expand market presence, and maximize technological impact globally.
Competitive Landscape
The antimicrobial susceptibility test market is highly competitive, with companies focusing on innovation, regional expansion, and strategic partnerships. Key players invest in R&D to enhance automation, molecular diagnostics, and AI-driven tools. Collaboration with hospitals, research laboratories, and distributors supports market penetration and adoption. Technical support, training, and workflow optimization ensure effective utilization of technologies. Competitive strategies emphasize reliability, accuracy, affordability, and operational efficiency. Understanding competitor strategies and regional adoption patterns allows stakeholders to identify opportunities, differentiate solutions, and strengthen market positioning worldwide.
Challenges and Solutions
Challenges include high costs of advanced systems, limited skilled personnel, regulatory variations, and infrastructure constraints. Companies address these by offering scalable, cost-effective solutions, providing comprehensive training programs, and establishing local support networks. Tailored solutions for regional requirements ensure broader adoption, operational efficiency, and sustainable growth. Addressing these challenges enables laboratories to fully leverage technological advancements, improve clinical diagnostics, and enhance antimicrobial resistance monitoring globally.
Future Outlook
The antimicrobial susceptibility test market is expected to grow steadily as laboratories adopt automation, molecular diagnostics, AI, and digital tools. Emerging markets provide significant growth potential, while established regions continue to upgrade infrastructure and integrate advanced technologies. Companies investing in research, innovation, and regional expansion are poised to strengthen their global presence. Overall, technological advancements are transforming diagnostic laboratories, improving accuracy, efficiency, and patient outcomes, and driving sustainable growth in the global antimicrobial susceptibility test market.
- AI
- Vitamins
- Health
- Admin/office jobs
- News
- Art
- Causes
- Crafts
- Dance
- Drinks
- Film
- Fitness
- Food
- Jogos
- Gardening
- Health
- Início
- Literature
- Music
- Networking
- Outro
- Party
- Religion
- Shopping
- Sports
- Theater
- Wellness


